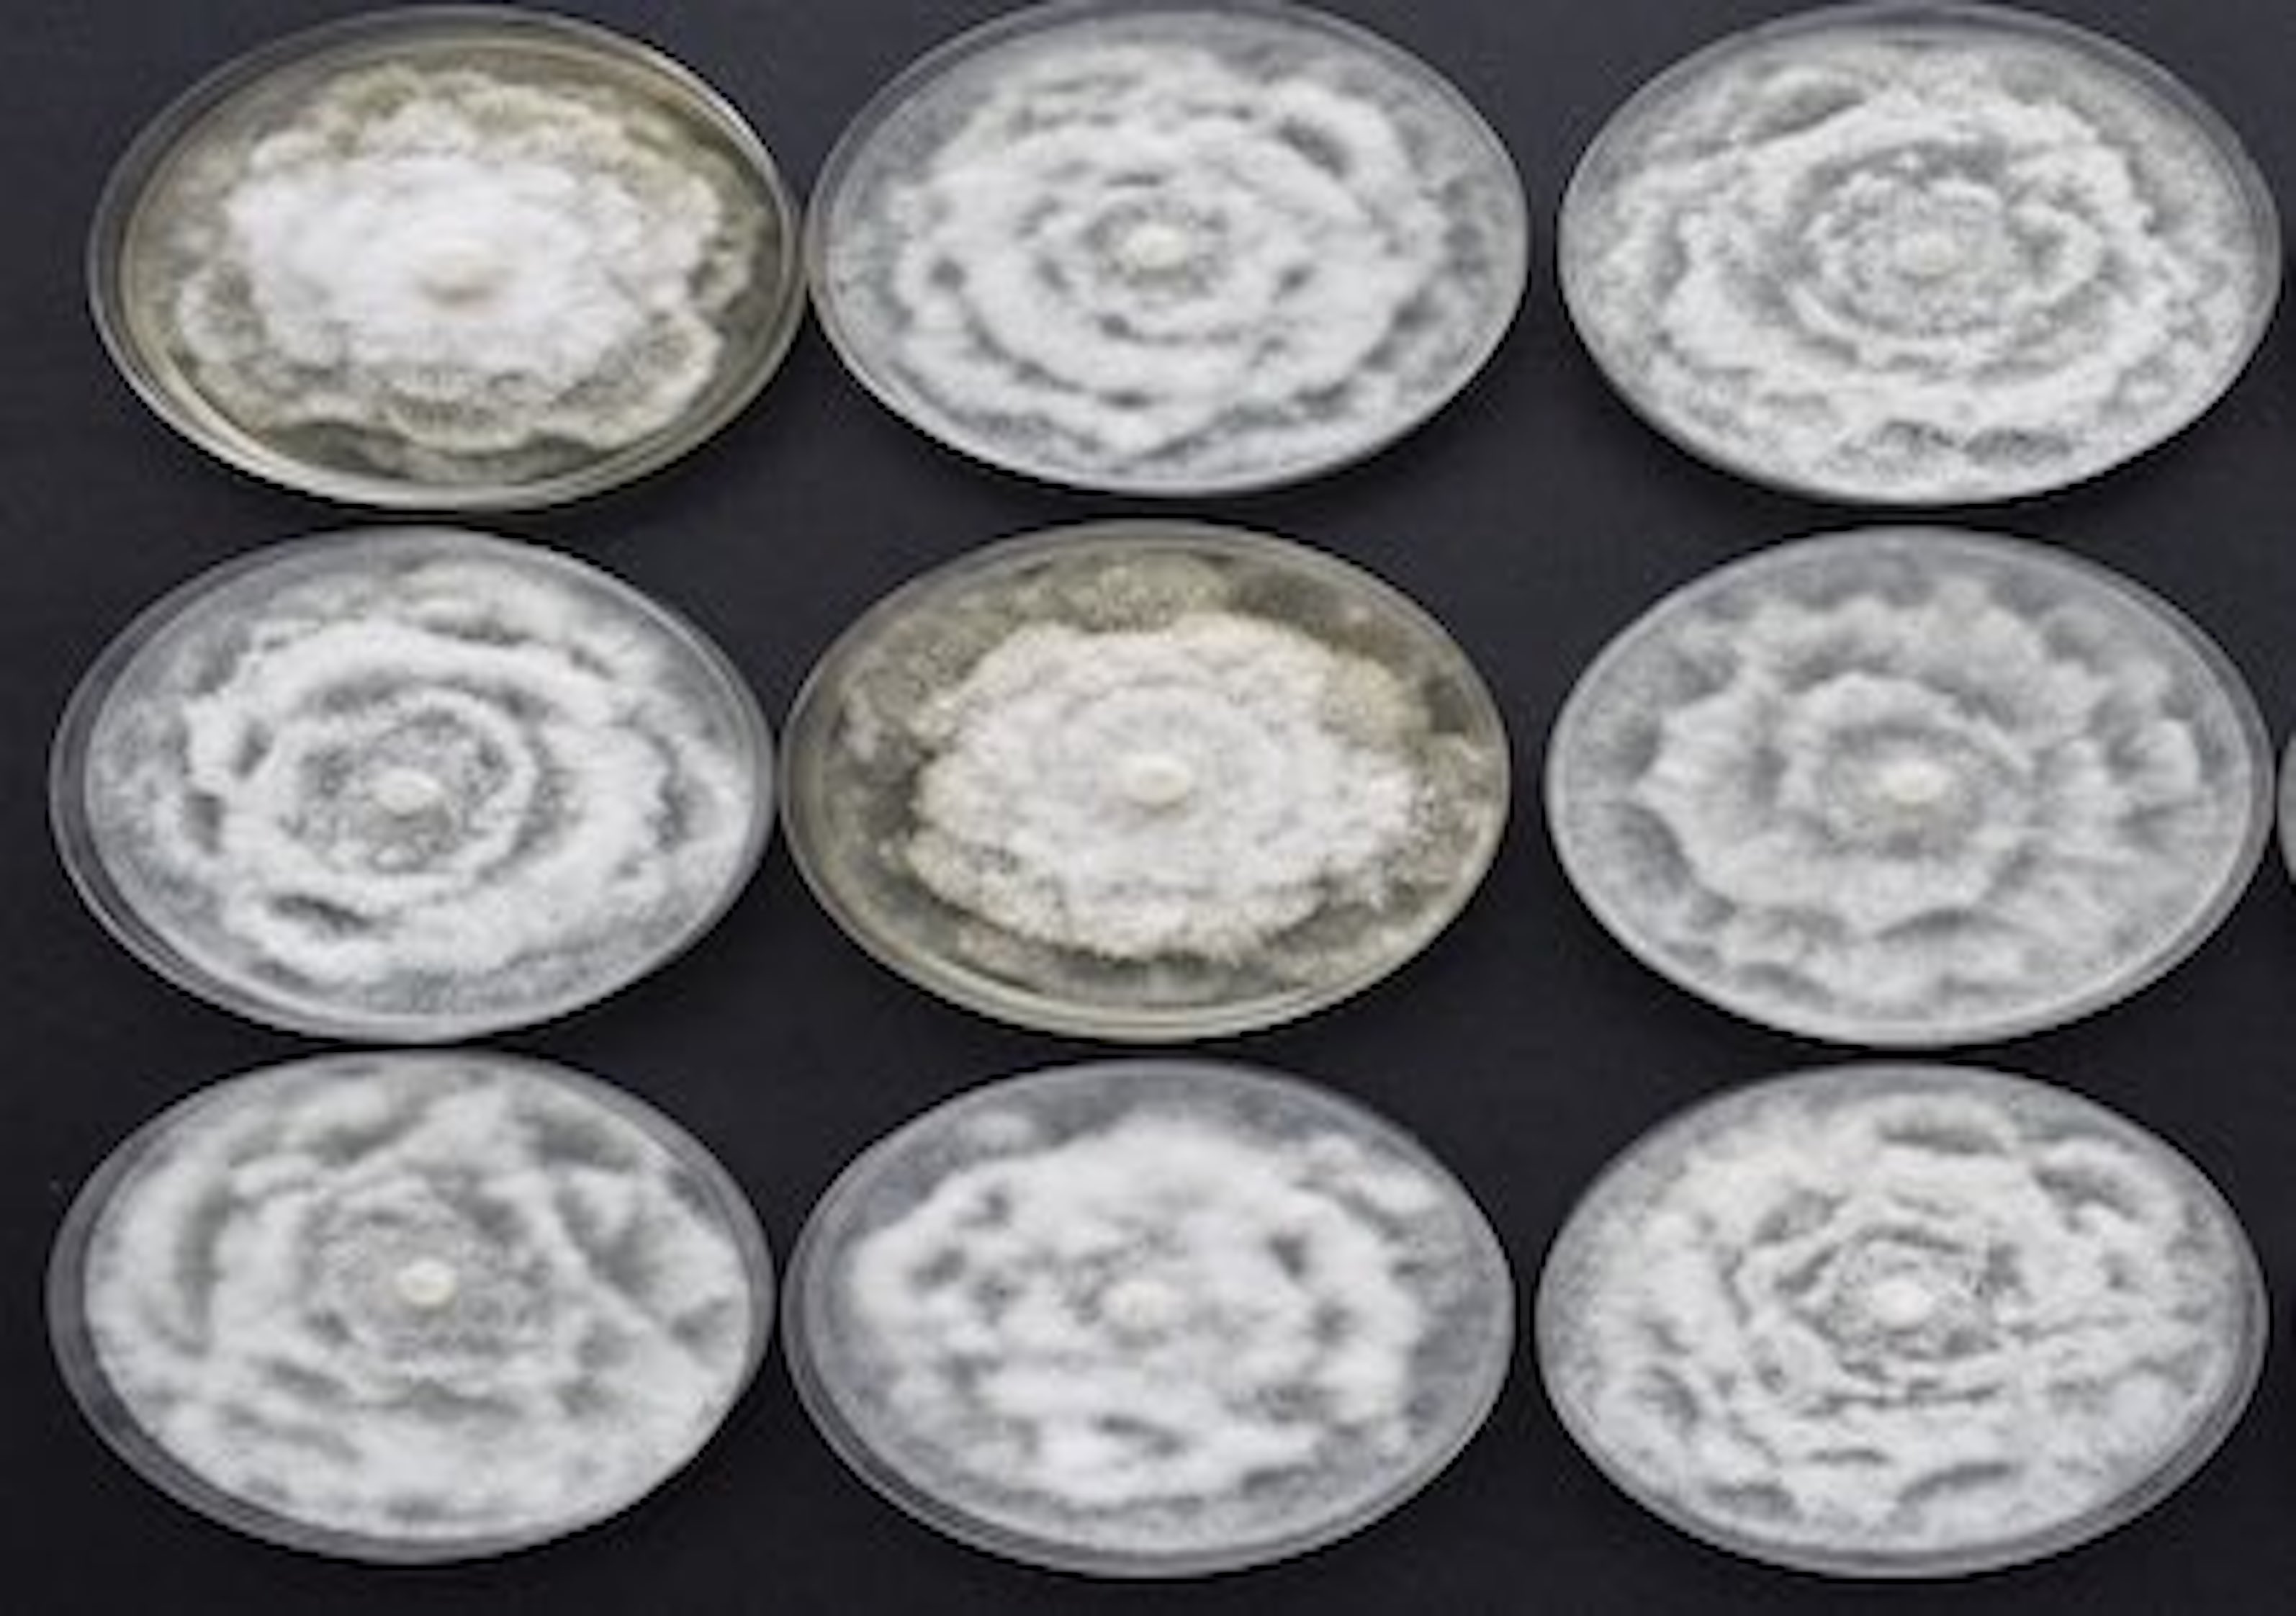

Lineas de trabajo
Sobre nosotros
Estrategia AGROS lo forman un grupo de profesionales en diferentes lineas de trabajo. Somos un equipo de carácter multidisciplinar, tanto por los cultivos que aborda (viticultura, olivicultura, fruticultura, horticultura, cereales) como por las disciplinas (agronomía del agua, técnicas de cultivo, malherbología, biología celular), con colaboraciones con grupos nacionales e internacionales.
Además, hemos podido enriquecer el desarrollo de algunas actividades contando con el apoyo de personal externo.

Fruticultura
El sector frutícola es un pilar imprescindible en la agricultura, con gran potencial de desarrollo y sujeto a constantes actuaciones que garanticen su rentabilidad. La implementación del riego garantiza la sostenibilidad de las producciones año tras año pero, en las condiciones actuales de baja disponibilidad de agua, requiere de estrategias agronómicas y mecanismos de control que permitan conocer la demanda hídrica de la planta y su estado hídrico, para alcanzar la mayor eficiencia en el uso del agua de riego y productividad del agua. Consultar nuestro equipo y nuestros proyectos.

Tecnología para la sostenibilidad
La tecnología está jugando un papel fundamental en el desarrollo de la agricultura, permitiendo que se produzca un gran avance en este sector en los últimos 20 años. La incorporación de la sensorización, la monitorización de cultivos con imágenes aéreas y satelitales, la robótica y la mejora en las comunicaciones están permitiendo que se puedan generar producciones más sostenibles, consiguiendo aumentar la productividad de los cultivos, reduciendo costes, haciendo un uso más racional de los insumos y aumentando la calidad. Consultar nuestro equipo y nuestros proyectos.

Fisiología de la producción vegetal
Conocer los procesos fisiológicos de las plantas y su capacidad de adaptación a los cambios medioambientales permite modificar su ciclo de desarrollo y crecimiento. Estos procesos fisiológicos están condicionados por la anatomía de los tejidos vegetales y por las características de las células que los integran. Esta línea analiza la los procesos biológicos y químicos de las células vegetales, el control o regulación de las funciones internas (fitohormonas) y la respuesta de las plantas al estrés (biótico y abiótico). Consultar nuestro equipo y nuestros proyectos.

Viticultura
La viticultura se enfrenta en la actualidad a grandes retos tanto agroclimáticos como técnicos, que obligan a un cambio en la gestión de los viñedos. La aplicación del riego, las técnicas de manejo o la selección de clones de variedades adaptadas a las condiciones de cultivo de cada zona, representa una potente herramienta para garantizar la rentabilidad del sector en el marco de la sostenibilidad y el uso eficiente de los recursos. Consultar nuestro equipo y nuestros proyectos.

Técnicas de cultivo
La finalidad del uso de los fertilizantes en los cultivos es obtener el máximo rendimiento y calidad en las cosechas. Sin embargo, es importante ajustar las dosis aplicadas a las necesidades del cultivo. En este sentido, la utilización de herramientas rápidas de diagnóstico nutricional es imprescindible para conocer en tiempo real las necesidades nutricionales del cultivo y adoptar las medidas necesarias. Consultar nuestro equipo y nuestros proyectos.
Protección vegetal
La protección vegetal tiene como objetivo mantener los cultivos sanos, protegiéndolos de los problemas fitosanitarios (enfermedades, plagas y malas hierbas) que pueden causar pérdidas importantes en los rendimientos. La gestión integrada se basa en el empleo de los métodos de protección de cultivos de forma integrada, reduciendo o minimizando los riesgos para la salud humana y el medio ambiente. Consultar nuestro equipo y nuestros proyectos.

Olivicultura
El olivar es el principal cultivo agrícola en Extremadura y a pesar de que ha sido un cultivo tradicional de secano, en la actualidad conviven junto con olivares intensivos y en seto bajo condiciones de riego. Este cambio tan singular de este ha hecho necesario poner en revisión trabajar muchos aspectos del cultivo. Desde estudiar las posibilidades de mecanización, potenciar el uso de variedades singulares, el diseño de las plantaciones, la poda, la gestión eficiente de agua y fertilizantes y el uso de cubiertas vegetales. Consultar nuestro equipo y nuestros proyectos.

Fruticultura de montaña
La fruticultura de montaña es una de las agriculturas que más está sufriendo los efectos derivados del cambio climático y la fuerte competencia del sector hortofrutícola, donde es necesario una mayor productividad para alcanzar beneficios que hagan rentables producciones locales minifundistas. Las estrategias de riego deficitario controlado y fertilización son fundamentales para mantener la productividad y la sostenibilidad de un cultivo altamente tradicional, con un marcado carácter fijador de la población. Consultar nuestro equipo y nuestros proyectos.

Encinas y alcornoques de regadío
La dehesa Extremeña está compuesta por numerosas especies arbórea entre las que destacan la encina y el alcornoque por sus producciones de bellota y corcho. Estos bosques en las últimas décadas han sufrido una degradación a causa de la Seca y necesitan de su regeneración. La introducción del riego como practica en estos sistemas, la selección del clones productivos y su posible propagación vegetativa y el uso de nuevos modelos productivos son necesarios para conseguir una recuperación rápida de estas especies arbóreas. En esta línea de trabajo de estudian todas estas cuestiones que son pilares básicos para el futuro de la dehesa. Consultar nuestro equipo y nuestros proyectos.
